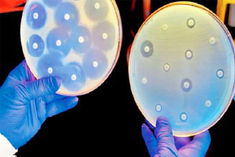

कोरोना वायरस के चलते जिनेवा इंटरनैशनल ऑटो शो और F8 Developer Conference रद्द
Posted On February 29th, 2020जापानी वैज्ञानिकों ने बनाया बच्चे की शक्ल का रोबोट, कर सकेगा दर्द महसूस
Posted On February 25th, 2020'न्यू इंडिया खासकर माताएं-बहनें पुराने ढर्रे पर चलने को नहीं तैयार, दिखा सकारात्मक बदलाव'
Posted On February 23rd, 2020'इंस्टाग्राम क्वीन' प्रियंका चोपड़ा के 50 मिलियन फॉलोअर्स पूरे, आगे हैं केवल विराट
Posted On February 23rd, 2020वैज्ञानिकों ने तैयार किया ऐसा एंटीबायोटिक जो ई-कोली जैसे खतरनाक बैक्टीरिया को भी कर देगा खत्म
Posted On February 23rd, 2020सुपरमॉडल ने लांच किया फीमेल वियाग्रा, कहा- इससे मेरी सेक्स लाइफ हुई बेहतर
Posted On February 22nd, 2020रेलवे ने स्टेशन पर लगाई एक्सरसाइज मशीन, उठक-बैठक पर मुफ्त प्लेटफॉर्म टिकट
Posted On February 22nd, 2020फूल और शैंपेन देने के लिए भारतीय मूल के व्यक्ति ने किया Apple सीईओ का पीछा
Posted On February 22nd, 2020इंटरनेटबंदी से संकट में भारतीय इकोनॉमी; 5 सालों में 19,435 करोड़ का नुकसान
Posted On February 21st, 2020दुनिया में पहली बार थ्रीडी प्रिटिंग की मदद से कान की हड्डी को किया गया दुरूस्त
Posted On February 20th, 2020चंद्रयान-2 में RR CAT की अहम भूमिका, उपलब्ध कराए थे चंद्रमा से निकलने वाले रेडिऐशन
Posted On February 20th, 2020वैज्ञानिकों ने बनाया स्मार्ट ब्रेसलेट, जो स्मार्ट स्पीकर को जाम कर नहीं होने देगा बातें लीक
Posted On February 19th, 2020परमाणु शक्ति से लैस पाकिस्तान की 'राड-2' मिसाइल लॉन्च, 600 किलोमीटर है मारक क्षमता
Posted On February 19th, 2020Advertisement